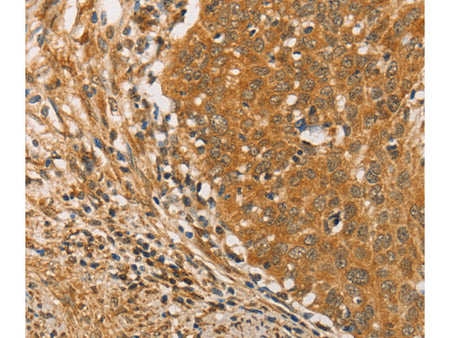
ARMCX3 Polyclonal Antibody Store at -20°C - MSE Supplies LLC

ARMCX3 Polyclonal Antibody Store at -20°C
Couldn't load pickup availability

Still have questions? Ask our experts!
ARMCX3 Polyclonal Antibody Store at -20°C
| SKU # | E-AB-10840 |
| Reactivity | Human, Mouse, Rat |
| Host | Rabbit |
| Applications | IHC |
Product Details
| Isotype | IgG |
| Host | Rabbit |
| Reactivity | Human, Mouse, Rat |
| Applications | IHC |
| Clonality | Polyclonal |
| Immunogen | Recombinant protein of human ARMCX3 |
| Abbre | ARMCX3 |
| Synonyms | 1200004E24Rik, 3, ALEX3, ARM protein lost in epithelial cancers on chromosome X 3, Arm protein lost in epithelial cancers, Armadillo repeat containing X linked protein 3, DKFZp781N1954, KIAA0443, MGC12199, X chromosome, dJ545K15.2 |
| Swissprot | |
| Cellular Localization | Membrane, Single-pass membrane protein. |
| Concentration | 0.3 mg/mL |
| Buffer | Phosphate buffered solution, pH 7.4, containing 0.05% stabilizer and 50% glycerol. |
| Purification Method | Affinity purification |
| Research Areas | Cancer, Epigenetics and Nuclear Signaling |
| Conjugation | Unconjugated |
| Storage | Store at -20°C Valid for 12 months. Avoid freeze / thaw cycles. |
| Shipping | The product is shipped with ice pack,upon receipt,store it immediately at the temperature recommended. |
Related Reagents
| Applications | Recommended Dilution |
| IHC | 1:50-1:200 |
Background
This gene encodes a member of the ALEX family of proteins which may play a role in tumor suppression. The encoded protein contains a potential N-terminal transmembrane domain and a single Armadillo (arm) repeat. Other proteins containing the arm repeat are involved in development, maintenance of tissue integrity, and tumorigenesis. This gene is closely localized with other family members on the X chromosome. Three transcript variants encoding the same protein have been identified for this gene.